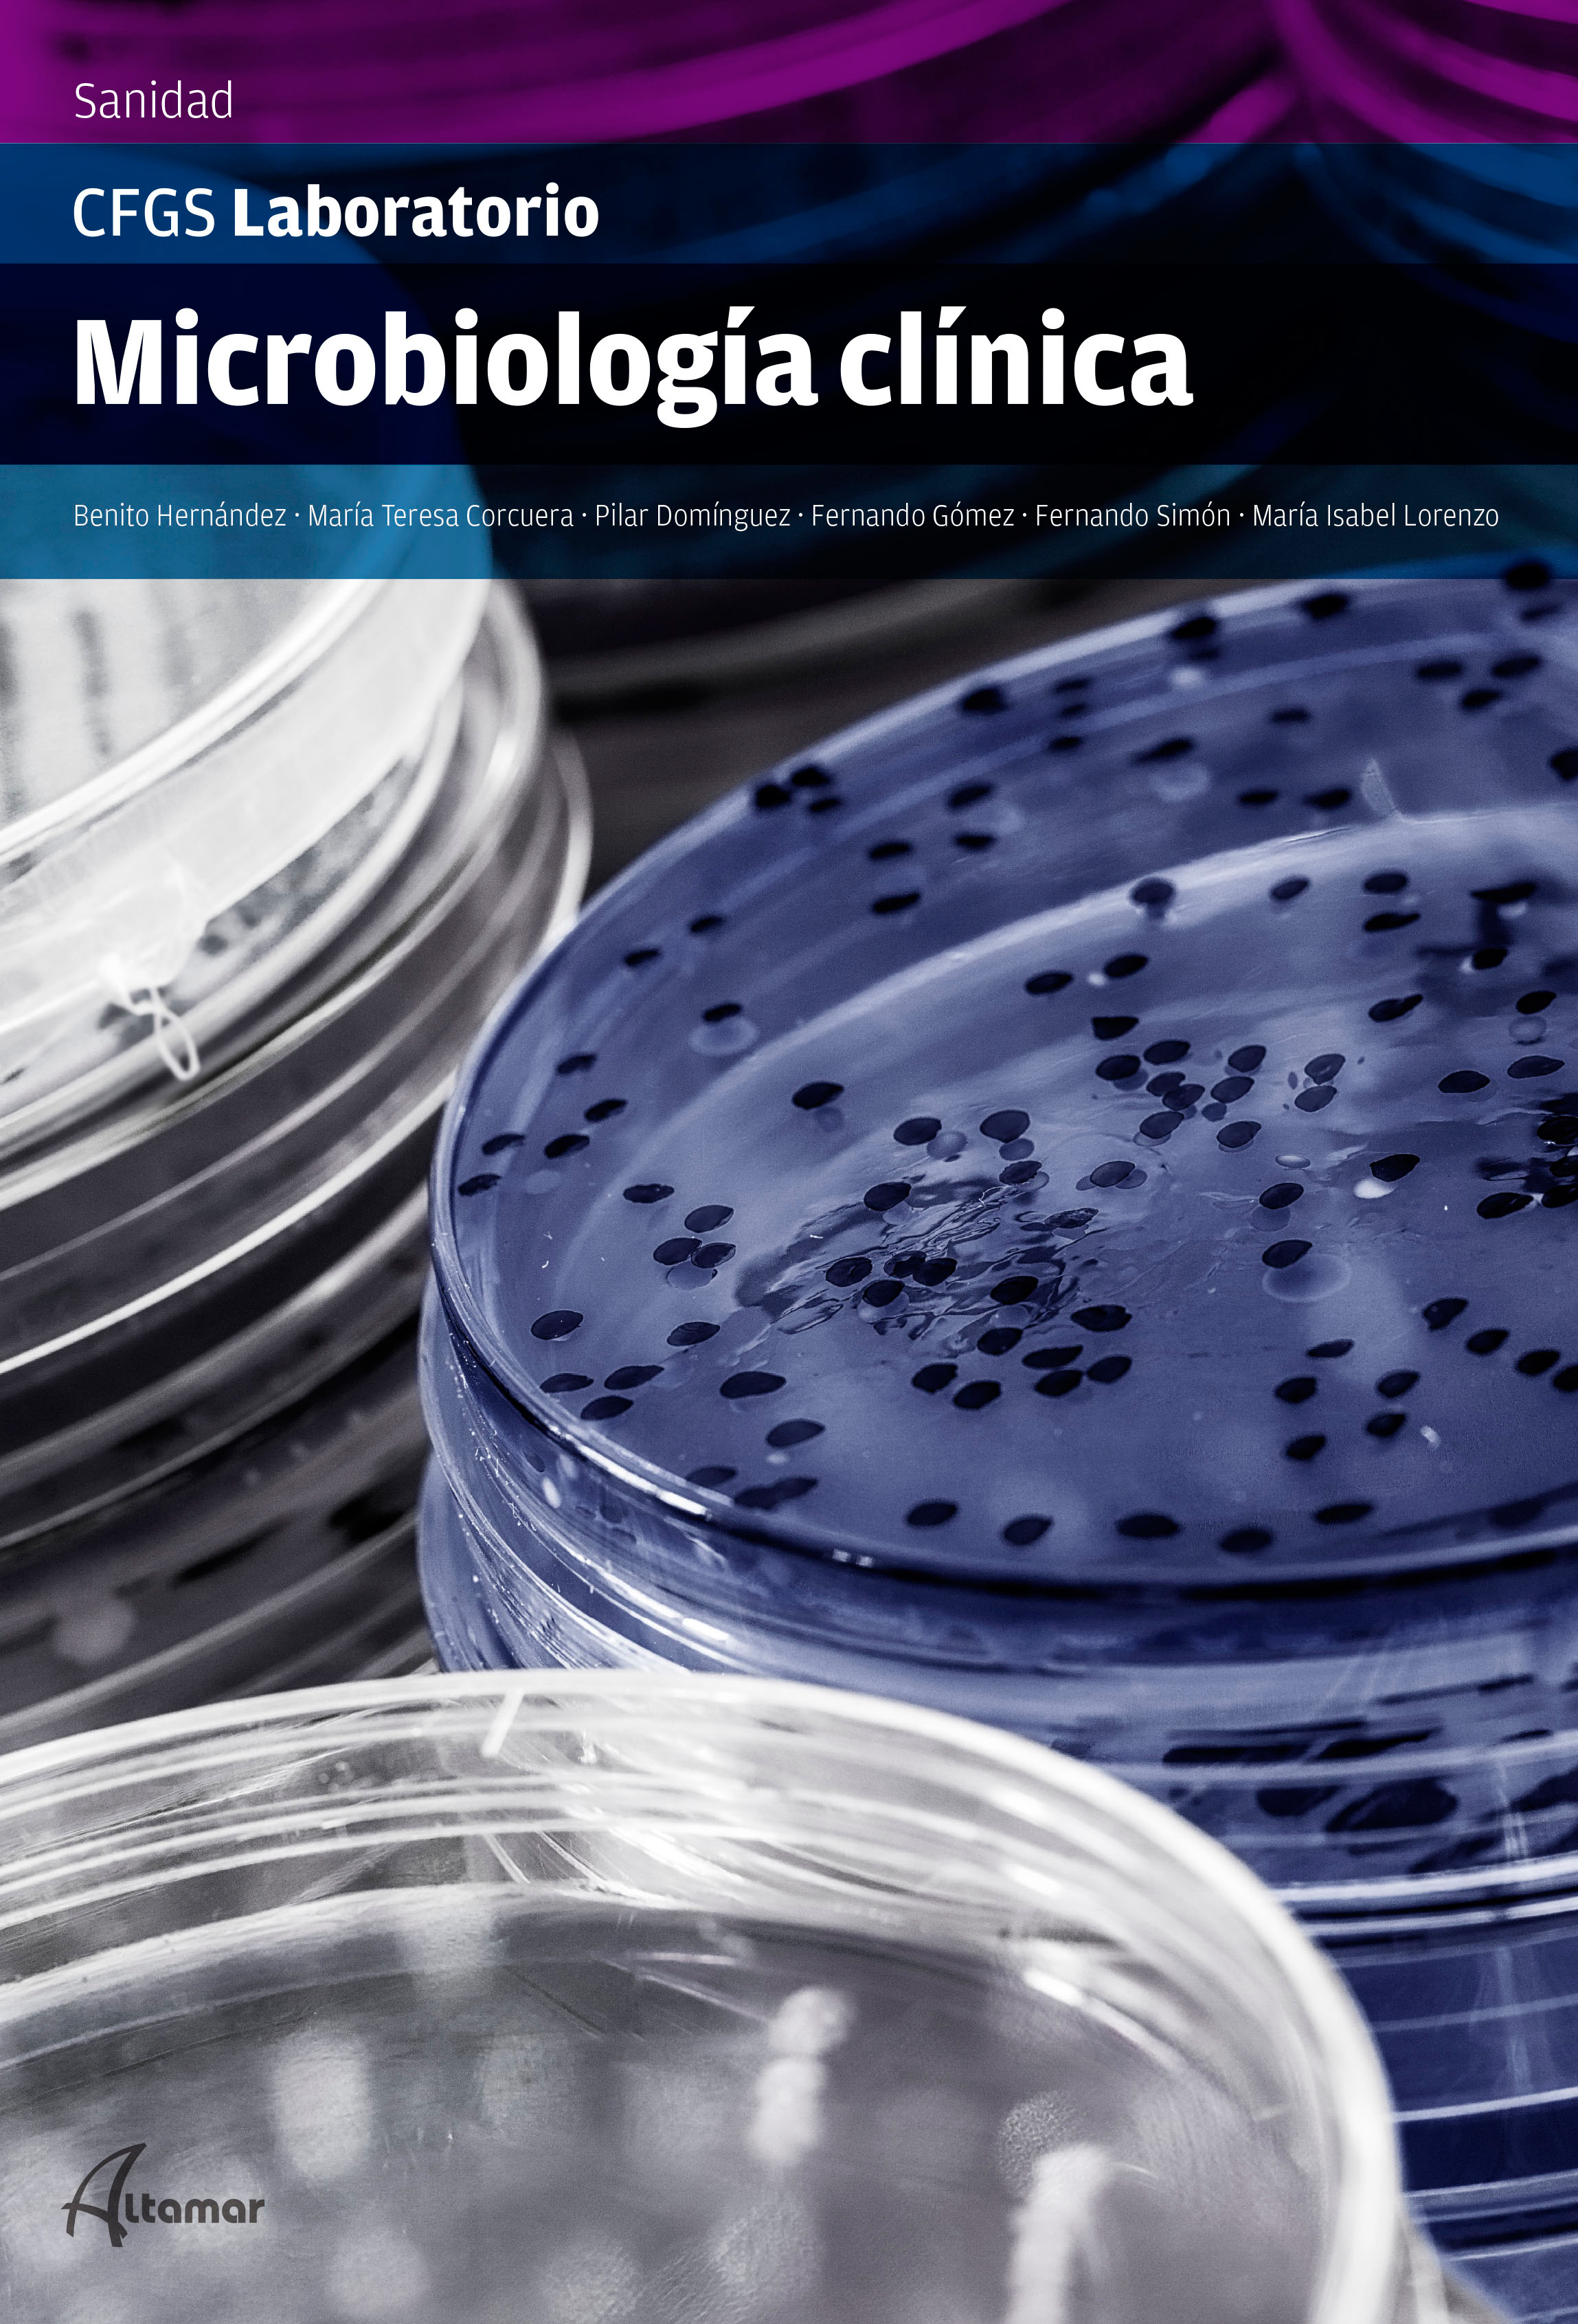

Apuntes completos microbiología enfermería comunitaria microbiología tema toma, conservación transporte de muestras. objetivo: identificación del agente. Este espacio está dividido en tres secciones: Apuntes universitarios, donde encontrarás documentos de Administración de Empresas, Bellas Artes, Biología, Derecho, Enfermería, Literatura, Periodismo, Psicología, entre otros; Apuntes de formación técnica, para aquellos que se preparan para trabajar en el sector Turismo, Cocina, Comercio, etc.; y Apuntes de enseñanza media, donde hay.

Guía práctica para técnico superior de laboratorio de diagnóstico clínico y biomédico ebook

Pin en Información de analisis clinicos

Máster en laboratorio. Especialista en análisis clínicos Formación Alcalá España

Henry. Diagnóstico Clínico y Técnicas de Laboratorio en LALEO

Microbiología y Biología Molecular. Diagnostico Clínico por Laboratorio Clostridium difficile

Fundamentos y Tecnicas de Analisis Bioquimico (Grado Superior. Laboratorio de Diagnostico

Apuntes de Microbiología Apuntes de Microbiología La microbiología deriva de 3 palabras

Portada de Laboratorio de Microbiología. Portadas de cuadernos, Cuadernos de dibujo, Cuadernos

Experto en Análisis de Muestras en el Laboratorio de Microbiología (130 horas) Enseñanza Dual

Laboratorio de microbiología Laboratorios Omega

Echevarne Microbiologia clínica

Apuntes DE Microbiologia Medica final APUNTES DE MICROBIOLOGÍA MÉDICA Diagnóstico, profilaxis

Laboratorio Micro Apuntes de Microbiología Docsity

Apuntes microbiología Docsity

Koneman diagnóstico microbiológico texto y atlas en color / Elmer W. Koneman...[et. al

Laboratorio de microbiología Laboratorios Omega

Apuntes bonitos Microbios Enseñanza de química, Bacteriologia, Apuntes de clase
Microbiología Clínica Altamar

Como montar um Laboratório de Microbiologia? Leia Mais

Apuntes bonitos Microbiología Medical school studying, Medical school, Study
Apuntes sobre la tuberculosis. El 24 de marzo de 1882, el Dr. Robert Koch dio a conocer su descubrimiento sobre la bacteria causante de la tuberculosis, Mycobacterium tuberculosis, también conocida como bacilo de Koch. Por esta razón, cada año se celebra en esta fecha el Día Mundial de la Tuberculosis para generar conciencia en la población acerca de la tuberculosis y sus efectos para la.. 1. Importancia de los apuntes en el laboratorio de diagnóstico clínico en microbiología. Los apuntes en el laboratorio de diagnóstico clínico en microbiología desempeñan un papel esencial en el proceso de análisis y diagnóstico de enfermedades.